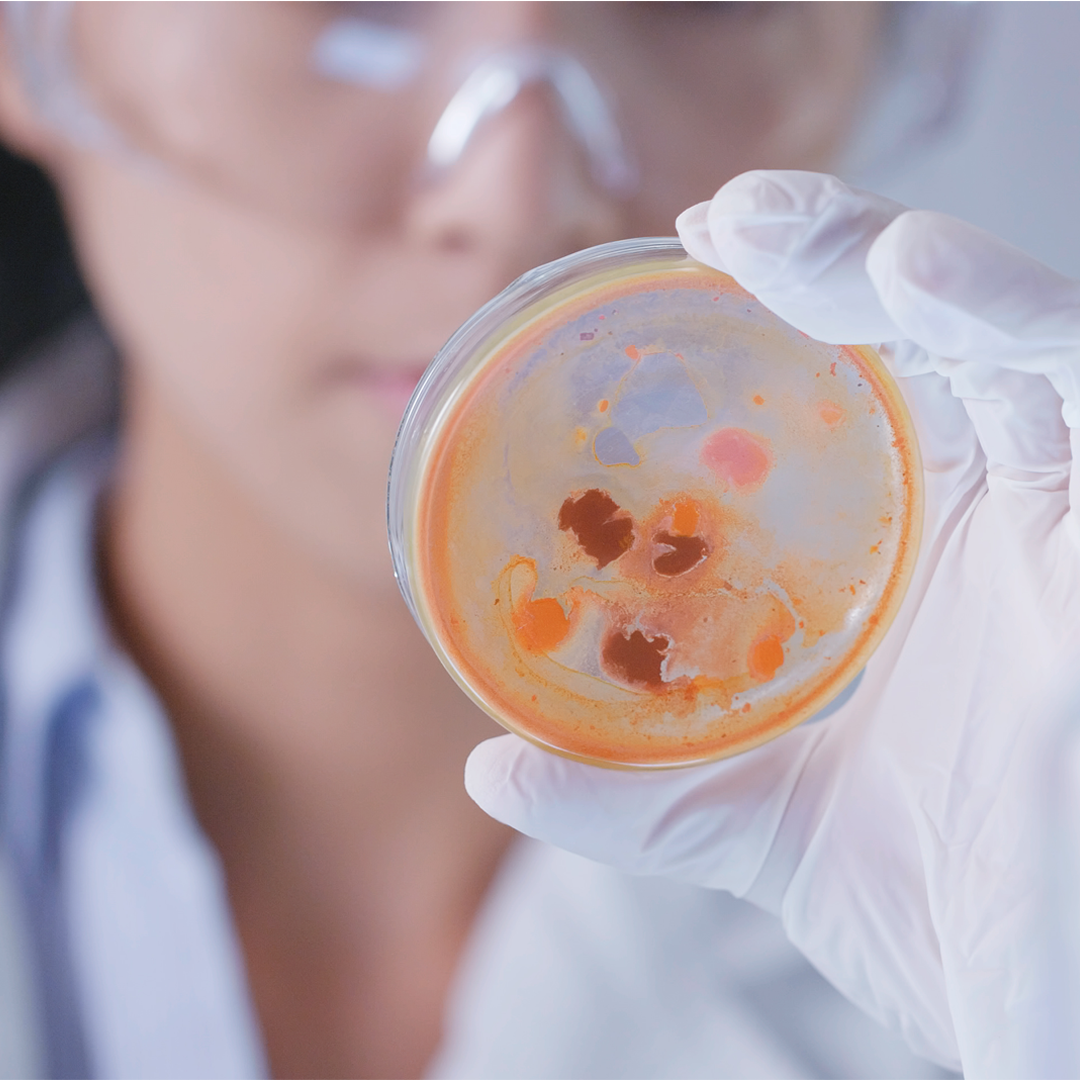

Services and Programs
Dr. Emre Güvercin Non Surgical: BotoxFillersLift TreatmentMesotherapyPRPStem Cell
How can we help you?
Dr. Emre Güvercin Aesthetic Clinic brings beauty together with art in Istanbul! It offers everything you need with safe, sterile and life-changing operations.
Aesthetic Touch with Dr. Emre Güvercin #FlyToBeauty
Dr. Emre Güvercin offers A+ service in the field of medical aesthetic and plastic surgery in his clinic in Ataşehir, the centre of Istanbul. With 35 healthcare professionals, Dr. Emre Güvercin, who goes beyond the usual methods, brings different solutions to his patients from all over the world.
HERE ARE SOME HELPFUL LINKS TO GET YOU ANSWERS FASTER.

Fly to Beauty now. Feel Better.
Time to discover your beauty! Register Online Before You Come.
Book an Appointment